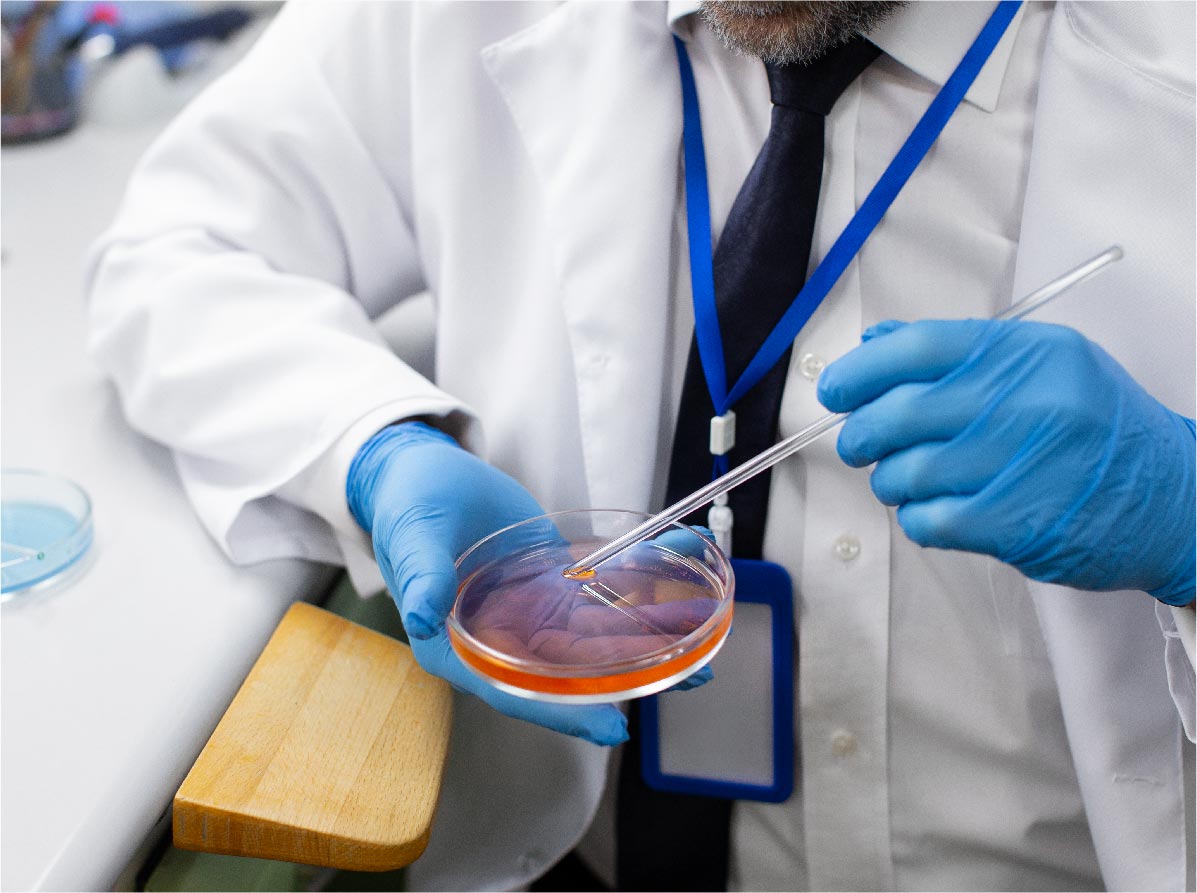

Low Sperm Count Treatment In Chandigarh
- Home
- Low Sperm Count Treatment In Chandigarh

Low Sperm Count Treatment
Fertility worries can shake any couple. The good news? Low Sperm Count Treatment In Chandigarh has advanced fast. At Dr. Sabia Mangat’s clinic, men can have clear answers, gentle care, and real hope. Many patients call her one of the best doctors for low sperm count treatment in Chandigarh because she listens first and treats later. This blog explains how a simple Semen Analysis Test in Chandigarh guides therapy and why timely help matters. It also shows how low sperm motility treatment in Chandigarh improves overall results.
Understanding Low Sperm Count
Low sperm count, or also known as oligospermia, means fewer than 15 million sperm per millilitre. Our centre offers low sperm count treatment in Chandigarh that looks at the full picture, not just numbers. First, we rule out hidden infections. We also scan hormone levels and analyse DNA fragmentation.. This step-by-step approach sets Dr. Mangat apart from other doctors for low sperm count in Chandigarh.
Key Signs You Should Not Ignore
- Trouble conceiving after a year of unprotected sex
- Low sex drive or erectile issues
- Pain, swelling, or lumps in the testicle area
If you tick any box above, consider booking a Semen Analysis Test in Chandigarh without delay. Early diagnosis speeds up low sperm count treatment In Chandigarh and protects future fertility.

The Role of Semen Analysis
A semen study checks the count, shape, and swimming speed of sperm in the sample. The results can guide the treatment of low sperm motility treatment in Chandigarh by pinpointing weak links. At our lab, reports are ready within 2-3 hours. The results are then reviewed by Dr. Mangat, one of the best doctors for low sperm count treatment in Chandigarh.
Common Causes We Treat
- Varicocele
- Hormonal imbalance
- Lifestyle habits like heavy smoking or drinking or long laptop use on lap
- Past infections
- Genetic issues
- Medical disorders like diabetes, hypertension, obesity
Low Sperm Motility Treatment in Chandigarh
Advanced Options at Dr. Sabia Mangat’s Clinic
- Hormone therapy to correct FSH, LH, or hormone deficiencies
- Microsurgical varicocelectomy for enlarged veins
- Assisted reproduction— IUI or IVF with ICSI, when indicated
- Cryopreservation to freeze sperm for later cycles

Lifestyle Changes That Boost Success
- Quit smoking and limit alcohol
- Excercise daily; 30-minute walks improves blood circulation
- Keep phones out of front pockets
- Eat zinc-rich foods like pumpkin seeds
- Sleep atleast seven hours
- Avoid processed foods
Such simple acts can support ongoing low sperm count treatment and improve motility too.

Importance of Timely Diagnosis

Cost and Transparency
Fees stay fair and clear. A standard Semen Analysis Test in Chandigarh costs less than a dinner out. Packages for low sperm motility treatment in Chandigarh come with price breakdowns. No surprise add-ons. You pay only for what you need.

Why Choose Dr. Sabia Mangat
Years of focused practice place her on every “Best Doctors For Low Sperm Count Treatment In Chandigarh” list. She runs the whole process herself—from first visit to final follow-up. Men feel safe discussing private worries. Partners feel heard. That human touch sets her above many doctors for low sperm count in Chandigarh.

FAQs About Tubal Block Treatment in Chandigarh
The first step is a Semen Analysis Test in Chandigarh. It checks your sperm count, shape, and motility, which helps doctors choose the right treatment.
Usually, the test is done twice to confirm the results. Follow-up tests are done every few months to track improvement.
No, not all. It’s best to consult experienced specialists like Dr. Sabia Mangat, who is among the best doctors for low sperm count treatment in Chandigarh and offers advanced treatment options.
Most men see improvements in sperm movement within three to six months, depending on the cause and lifestyle changes.
In many cases, yes. But sometimes you may need hormone therapy, minor surgery, or assisted reproduction. Every case is different.
Home remedies might help a little, but proper medical care by doctors for Low Sperm Count in Chandigarh gives faster and more reliable results.
No, it’s not painful at all. It’s a simple lab test done with a sample given at the clinic for accurate results.
Avoid smoking, reduce alcohol, wear loose underwear, and eat zinc-rich food. These changes help the treatment work better..
Patients call her one of the best doctors for low sperm count treatment In Chandigarh because she gives personalised care, explains everything clearly, and builds trust.
Yes, freezing sperm is a good option for future use, especially if you plan to delay pregnancy or go for IVF later.
When to See a Specialist
If you and your partner have been trying to conceive for over a year without success, it’s time to consult doctors for low sperm count in Chandigarh. Early evaluation and the right treatment can make a huge difference. Don’t delay out of fear or stigma; many couples go through this, and most find success with timely help. A simple Semen Analysis Test in Chandigarh can be the first step to a brighter future.
Ready to act? Book your first low sperm count treatment in Chandigarh today. Call the clinic or fill out our online form. Hope starts with one small step.
